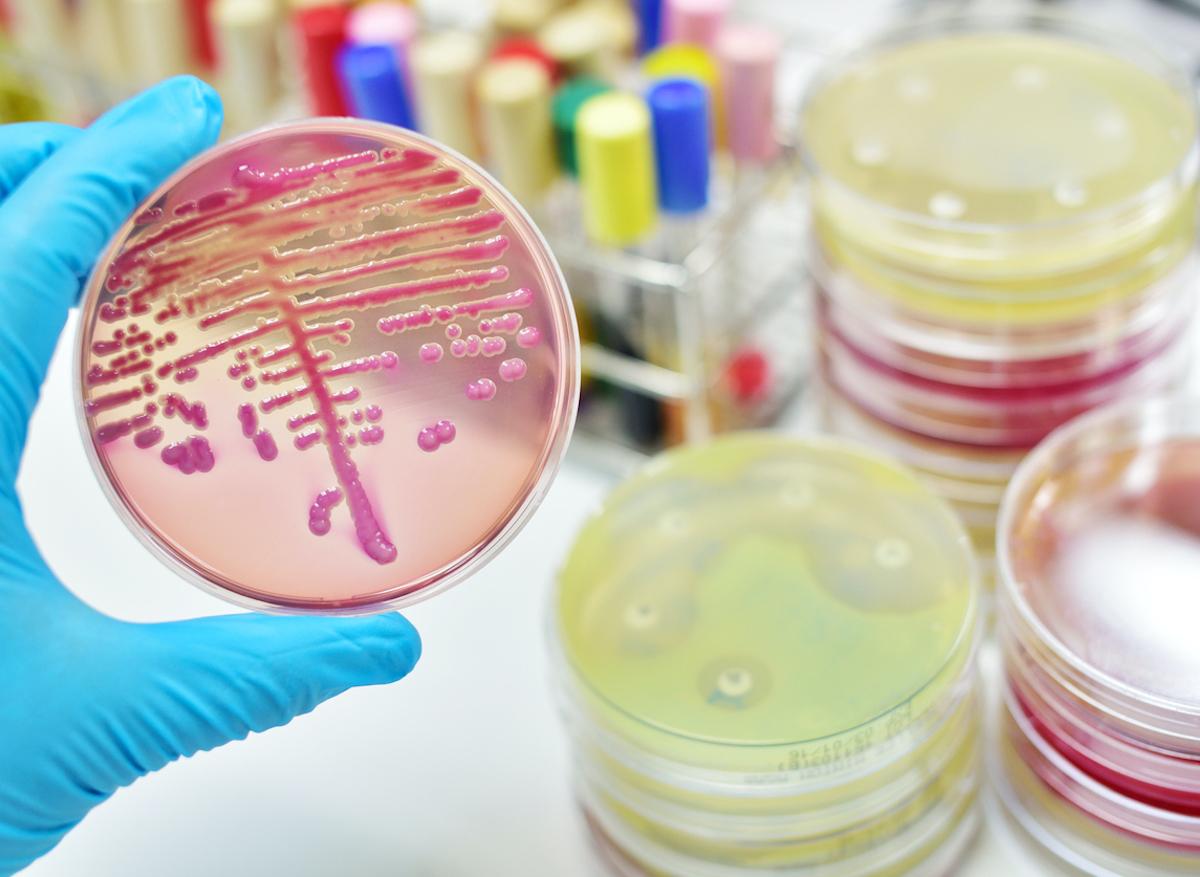

- Le SARM est résistant aux antibiotiques et les risques de développement d'une infection sont élevés.
- Le taux de mortalité grimpe de 18% à 36% chez les porteurs du SARM.
À moins de développer une infection ou d'être soumis à un test de dépistage de la bactérie, il est généralement difficile de savoir si l'on porte ou non ce staphylocoque. "Très peu de personnes porteuses de SARM savent qu'elles possèdent cette bactérie, mais nous avons trouvé un lien distinct entre les personnes porteuses de SARM non détecté et les décès prématurés", affirme l'auteur principal de l'étude, Arch G. Mainous.
Le SARM s’avère d’autant plus difficile à traiter qu’il se montre résistant aux antibiotiques. Les patients hospitalisés avec un SARM colonisé peuvent être particulièrement vulnérables au développement d'une infection pendant un séjour à l'hôpital ou après leur sortie. Les plaies, les incisions chirurgicales et l'utilisation de dispositifs médicaux, tels que les cathéters, peuvent également entraîner une infection à SARM chez les porteurs.
Parue dans le Journal of American Board Family Medicine, l’étude a été réalisée à partir de données de la National Health and Nutrition Examination Survey, vaste étude nationale réalisée entre 2001 et 2004, qui combine des questions d'enquête et des tests de laboratoire, notamment des prélèvements nasaux pour détecter la présence de SARM.
Un taux de mortalité qui grimpe 18% à 36% pour le SARM
Les chercheurs ont comparé les données et les décès des participants âgés de 40 à 85 ans à ceux correspondant à l'index national des décès sur une période de 11 ans. Les chercheurs ont tenu compte de nombreux potentiels facteurs de confusion (sexe, origine ethnique, revenus des patients, hospitalisation au cours des 12 mois précédents et diagnostic médical de maladie cardiaque, de diabète et d'asthme.)
Les auteurs de l'étude ont constaté que le taux de mortalité chez les participants sans SARM était d'environ 18%, mais que chez les porteurs du SARM, ce taux grimpait à 36%. Ce risque accru de décès prématuré n'a pas été observé chez les participants porteurs de staphylocoques sur la peau, mais dénués de SARM. "Sans une stratégie uniforme, nous manquons une occasion d'aider à prévenir les décès causés par le SARM", insiste le Pr Mainous.
Selon un rapport des Centers for Disease Control and Prevention, 119 000 Américains ont été victimes d'une infection sanguine à staphylocoque en 2017 et près de 20 000 en sont morts.